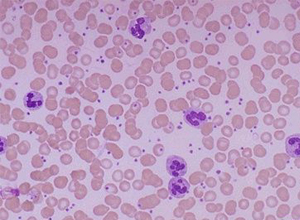
补硒三个月免疫力(补硒增强免疫力)-硒宝网

补硒三个月免疫力(补硒增强免疫力)
【相似文献】
中国期刊全文数据库
前20条
李云;;每天6个1提高免疫力[J];现代妇女;2006年02期
;每天六个一提高免疫力[J];学生之友(初中版)(中考);2009年08期
岳学状,张蕴琨,王雪梅;运动与促炎性细胞因子[J];南京体育学院学报(自然科学版);2002年02期
小舞;;运动让延缓衰老不仅仅是个梦[J];健康管理;2010年09期
艾冬生,栗丽;急性运动与非特异性免疫[J];中国临床康复;2003年06期
李利根;柴家科;曹卫红;李峰;冯光;;重度烧伤患者免疫细胞凋亡及单核细胞HLA-DR抗原表达改变及意义[J];西南国防医药;2006年05期
杨超元;;如何增强人体免疫力[J];保健医苑;2008年12期
黄惠娟;钟小宁;;慢性阻塞性肺疾病与免疫[J];细胞与分子免疫学杂志;2010年03期
叶路;杨亚军;韩景田;;谷氨酰胺对运动小鼠血清中免疫指标的影响[J];职业与健康;2009年21期
10
王今越;王小虹;陈民盛;;核转录因子κB与肌细胞的生长和运动[J];中国组织工程研究与临床康复;2009年50期
11

余鲁军,於卓清,孙开宏;β-内啡肽对免疫细胞的影响及其运动时的反应[J];中国临床康复;2001年21期
12
王恩;金国飞;;白细胞与脑梗死[J];心脑血管病防治;2010年05期
13
曾飒;罗高琴;刘德育;;蛇葡萄素对免疫细胞的趋化作用[J];中药材;2006年03期
14
李芝秀;陈权彰;谭自民;孙公凯;董国权;李祖秀;;七十岁以上老人免疫细胞的检测与分析[J];贵州医药;1984年04期
15
林新;;秋冬如何提高你的免疫力[J];就业与保障;2007年12期
16
杨静;刘洪斌;李东华;张艳萍;杨秀竹;;脓毒症大鼠外周血免疫细胞相关黏附分子的表达[J];中国中西医结合外科杂志;2009年06期
17
郭建军,杨则宜,王左敏,许葆华;不同硒营养和运动对小鼠免疫和抗氧化功能的影响[J];营养学报;1999年03期
18

杨俊卿;运动性晕厥的常见原因和预防措施[J];北京体育师范学院学报;1999年02期
19
肖德生,钱忠明;运动诱导的低铁状态大鼠骨髓细胞铁摄入的变化[J];生理学报;2000年02期
20
杨晓冰,吴毅,李益明,李云霞,占飞,胡永善,朱尚权,平蓓芳;运动促进大鼠骨骼肌细胞葡萄糖运载体4的转位[J];中国运动医学杂志;2000年01期
中国重要会议论文全文数据库
前10条
于一;郭艳芳;张秀兰;;神经肽对吞噬细胞功能的影响[A];中国细胞生物学学会第五次会议论文摘要汇编[C];1992年
潘明鸣;孙铁英;张洪胜;;慢性持续期哮喘患者外周血中性粒细胞和单核细胞Toll样受体的表达及意义[A];中华医学会第七届全国哮喘学术会议暨中国哮喘联盟第三次大会论文汇编[C];2010年
邹小立;;获得性中性粒细胞缺乏症医院感染疗效分析[A];中华医院管理学会第十一届全国医院感染管理学术年会论文汇编[C];2004年
王云霞;刘磊;龙飞;蒋春雷;;糖皮质激素快速抑制炎细胞反应的非基因组机制[A];中国神经科学学会第六届学术会议暨学会成立十周年庆祝大会论文摘要汇编[C];2005年
尚东;王宝枝;齐清会;陈海龙;毕伟;关凤林;;中性粒细胞凋亡调控基因表达异常在全身炎症反应综合征中的作用[A];第十届全国中西医结合普通外科学术会议暨胆道胰腺疾病新进展学习班论文汇编[C];2006年
杨学农;徐琳;杨晓荣;;非化脓菌感染引起的中性粒细胞类白血病反应的诊断分析[A];第五次全国中青年检验医学学术会议论文汇编[C];2006年
邓新立;;重组人粒细胞集落刺激因子对中性粒细胞及其表面分子表达的影响[A];第五次全国中青年检验医学学术会议论文汇编[C];2006年

李崇巍;黄敬孚;许俐;胡坚;;中性粒细胞表达CD64在小儿风湿性疾病中的应用[A];全国自身免疫性疾病专题研讨会暨第十一次全国风湿病学学术年会论文汇编[C];2006年
魏扬;倪龙娟;陆晓萍;;47例感染相关性粒细胞减少症分析[A];2006(第三届)江浙沪儿科学术会议暨浙江省儿科学术年会论文汇编[C];2006年
10
步军;黄萍;孙建华;;早产新生儿中性粒细胞活性氧代谢的研究[A];中华医学会第十四次全国儿科学术会议论文汇编[C];2006年
中国博士学位论文全文数据库
前10条
贺艳杰;中华眼镜蛇毒组分联合活化免疫细胞对hu-Balb/c-nu-KG1a白血病的治疗作用[D];南方医科大学;2010年
薛庆亮;中性粒细胞内皮质醇与炎症反应关系的研究[D];中国人民解放军军医进修学院;2011年
王珊;免疫细胞细胞胞内死亡特征及机制研究[D];华南理工大学;2012年
马婧薇;天然免疫细胞产生的微颗粒在肝癌细胞侵袭和转移中的作用及其机制[D];华中科技大学;2012年
曹平平;不同类型CRS的免疫病理学特性及其机制的初步探讨[D];华中科技大学;2011年
王聪华;CD147在类风湿关节炎中性粒细胞中的表达及作用研究[D];第四军医大学;2010年
王学富;药物诱导肝脏损伤的免疫学机制及人源化小鼠中B细胞特性研究[D];中国科学技术大学;2012年
赵丽云;阿片类药物对PMN NF-kappaB基因及PMN凋亡的影响[D];中国协和医科大学;2004年
孙华君;移植肾急慢性功能丧失与急性排斥炎细胞浸润相关性研究[D];吉林大学;2012年
10
赵正源;中性粒细胞弹性蛋白酶在肺癌发生发展中的作用[D];第四军医大学;2004年
中国硕士学位论文全文数据库
前10条
王中英;1-磷酸鞘氨醇对粒细胞功能的影响及其信号通路的初步研究[D];华东师范大学;2012年
陈志凤;一种基于免疫原理的入侵检测模型的设计与实现[D];武汉科技大学;2007年
袁园;白色念珠菌腹腔感染对脾虚小鼠致病性的研究[D];辽宁中医药大学;2007年
康虹阳;突发事件人员救护中血液中性粒细胞快速测定方法的探讨[D];重庆医科大学;2010年
郑彦涛;急性感染时中性粒细胞功能与活性的变化及其他外科临床研究[D];南方医科大学;2011年
朱序勤;罗哌卡因对炎症反应中的中性粒细胞功能影响及其作用机制的探讨[D];复旦大学;2010年
张冀松;中性粒细胞凋亡及调控与慢性阻塞性肺疾病发病机制的关系[D];复旦大学;2010年
翁四维;粘结剂对人中性粒细胞的影响[D];南京医科大学;2012年
高小平;猪链球菌2型与猪中性粒细胞相互作用研究[D];华中农业大学;2012年

10
张赟健;丙戊酸钠对中性粒细胞氧化代谢与机体氧化应激影响的研究[D];复旦大学;2011年
中国重要报纸全文数据库
前10条
王雪飞;非免疫细胞也产生免疫球蛋白[N];健康报;2004年
健康时报实习记者 张鹏飞;运动超1小时降低免疫力[N];健康时报;2009年
余川;捶背可提高免疫力[N];中国中医药报;2006年
余川;捶背可提高免疫力[N];中国中医药报;2006年
葛秋芳;免疫细胞可能促进癌细胞生长[N];新华每日电讯;2008年
记者张冬素;“策反”肿瘤细胞“卫兵”[N];浙江日报;2005年
记者 顾钢;德发现多发性硬化症新机理[N];科技日报;2007年
夏洪平 译;免疫细胞将“上阵”治癌症[N];健康报;2005年
伍新华;擦胸捶背可提高免疫力[N];卫生与生活报;2007年
10
张景勇;非免疫细胞也可产生免疫球蛋白[N];医药经济报;2004年
